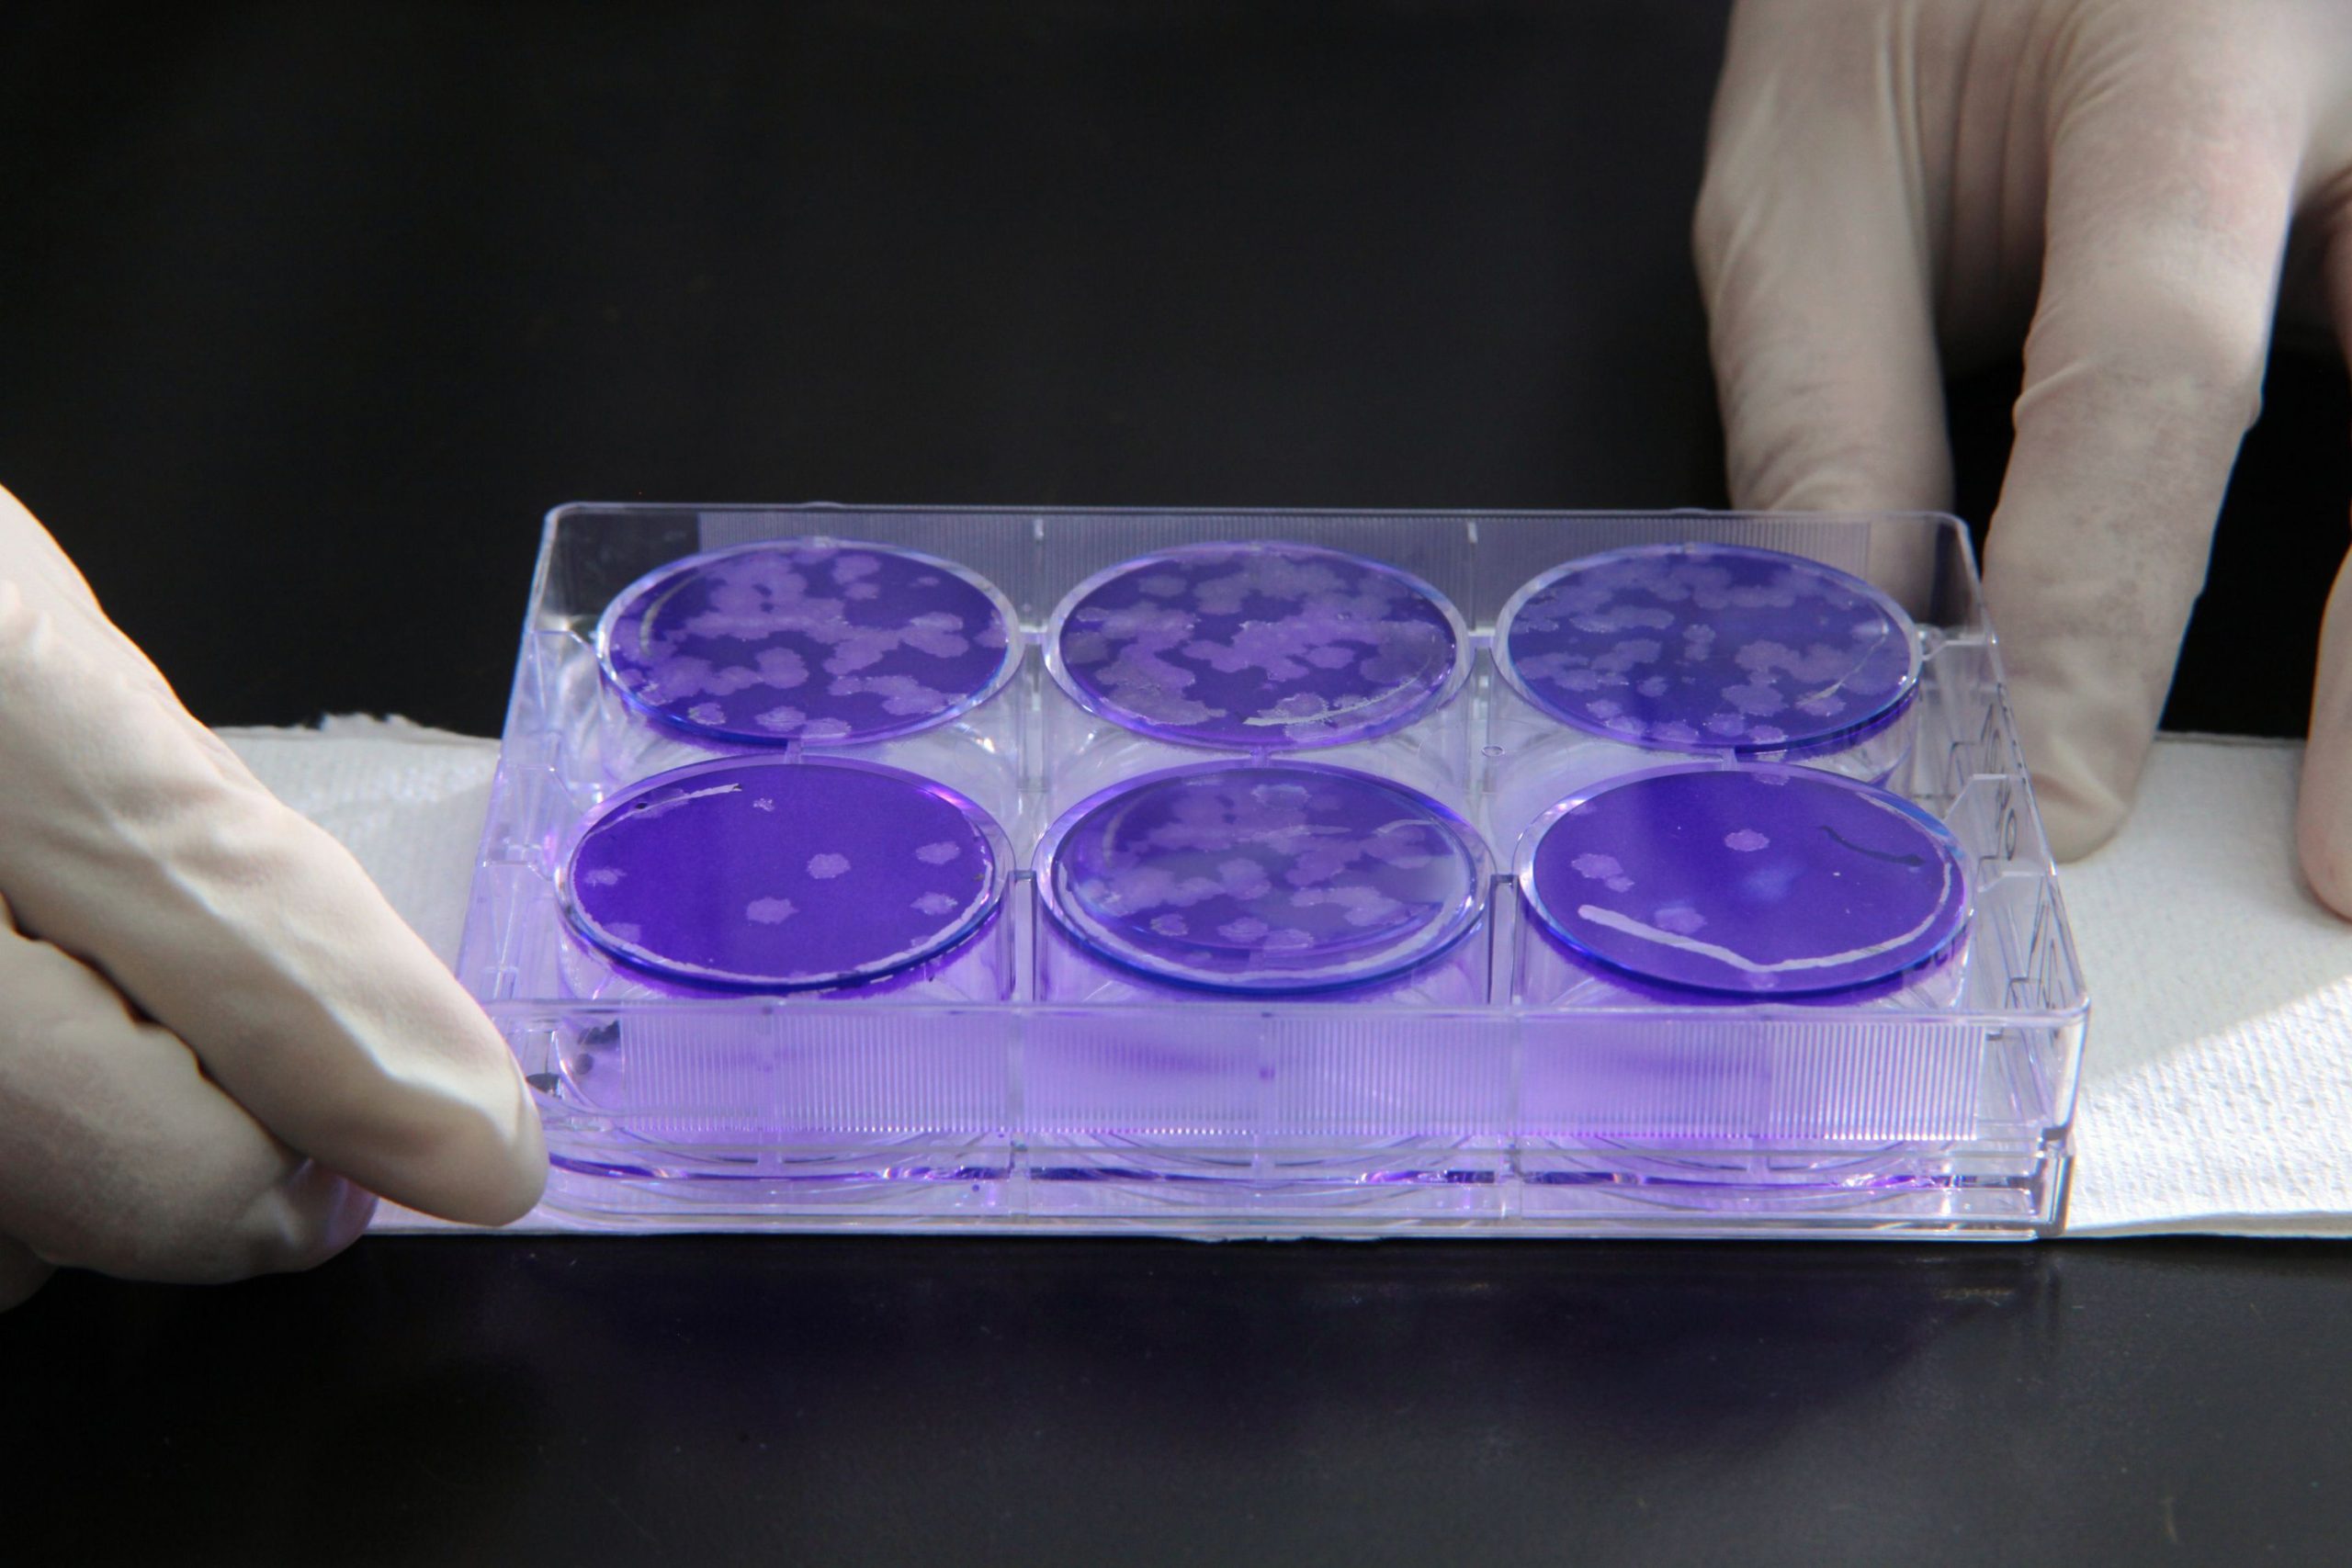
Mycoplasma

Biopharmaceuticals
Due to the inherent risks of biopharmaceuticals – vaccines, monoclonal antibodies, recombinant proteins, blood derivatives, animal tissue derived products, etc. – a variety of quality and safety testing is required by the FDA. Our industry experience and deep knowledge in this industry will help ensure the ultimate safety and compliance of your product.

Biopharmaceutical Testing
At Microbac, we specialize in biopharmaceutical testing to support the development and approval of biologically derived drugs, including proteins, monoclonal antibodies, and vaccines. Our comprehensive testing services—ranging from cell and tissue-based assays to potency and molecular characterization—are designed to ensure the safety, quality, and efficacy of your products. We work closely with clients to meet regulatory requirements and provide reliable, data-driven insights at every stage of development.
Regulatory Guidance and testing:
-
Adventitious virus
-
Disinfectant qualification efficacy test (DQ/DET) – microbes and viruses
-
Real time quantitative PCR
-
Residual DNA
-
Transmissible Spongiform Encephalopathy (TSE)-Clearance Study
-
Viral clearance

Viral Clearance
Biopharmaceutical products have an inherent risk of transmitting infectious viruses due to variables in source materials, manufacturing processes and the route of administration employed throughout production. In order to mitigate the viral contamination risk, we work with client project teams on a multi-faceted, complementary approach, including selecting and testing the starting materials, direct testing of the product at various stages of production, and incorporating and validating viral inactivation and removal steps (i.e., “viral clearance” studies).

Adventitious Virus
Biologics have an inherent risk of viral contamination. In order to mitigate the viral contamination risk, we work with clients on a tried and true approach required by regulatory authorities. We collaborate closely with client teams on selecting and testing the starting materials, direct testing of the product at various stages of production, and incorporating and validating viral clearance steps.

Disinfectant Qualification
Biopharmaceutical manufacturers are required to maintain sterile areas for production. The FDA requires that all cleaning and disinfection procedures using disinfectants and sanitizers in these areas and on these surfaces must be validated.
Testing involves evaluating products and procedures used to decontaminate devices and multiple surface areas within assigned sterile spaces.
Testing is based on USP 1072 but can be customized based on the needs of the client.

Residual DNA
When animal tissues are used for treatment of human disease, it is important to make sure animal DNA is removed to a sufficient level, as defined by the FDA, depending on the intended use of the tissue. In this type of study, the tissue is thoroughly digested using heat, a strong detergent, and enzymatic action overnight. Present DNA is extracted using a commercial kit.
Microbac can quantify available DNA using a dye that binds to dsDNA (double-stranded DNA), studying it along with a standard curve of known DNA concentration. OD260/280 is usually also taken for these tests to quantify the purity of any present DNA.
Mycoplasma
Cell cultures are often contaminated with small bacteria known as mycoplasma. If the cells are to be used for human treatment or to make a product, the FDA requires they be tested for the absence of mycoplasma routinely to be sure the final product will be safe for human use. Microbac is highly experienced with this type of testing.
Mycoplasma can be detected using any of the following methods offered by Microbac:
- Culture
- Vero cell co-culture
- PCR targeting regions of DNA specific to mycoplasma – the most common and readily available of these detection pathways

In Vitro Toxicology
We perform toxicity testing and toxicological screening studied in vitro on a variety of products, such as pharmaceuticals, biopharmaceuticals, medical devices, cosmetics, personal care products, disinfectants, special chemicals, and tobacco, etc. Over the past few decades, testing toxicity using non-animal methods (in vitro, ex vivo, and in silica) have become more and more popular thanks to the advancement of science, collaborative development and validation efforts, consumer pressure and regulatory acceptance.

Transmissible Spongiform Encephalopathy (TSE)-Clearance Study
Biological products that are derived from cattle are evaluated for the risk of containing TSE (prion) agents. In addition to control of the source of the bovine materials, a TSE-clearance study may need to be performed to ensure the capacity of the manufacturing process to remove and/or inactivate TSE agents.

Contact Us
Have questions or need expert testing solutions? Reach out to Microbac today, and let our team provide you with reliable and accurate testing services tailored to your needs. We’re here to support your business with trusted expertise.